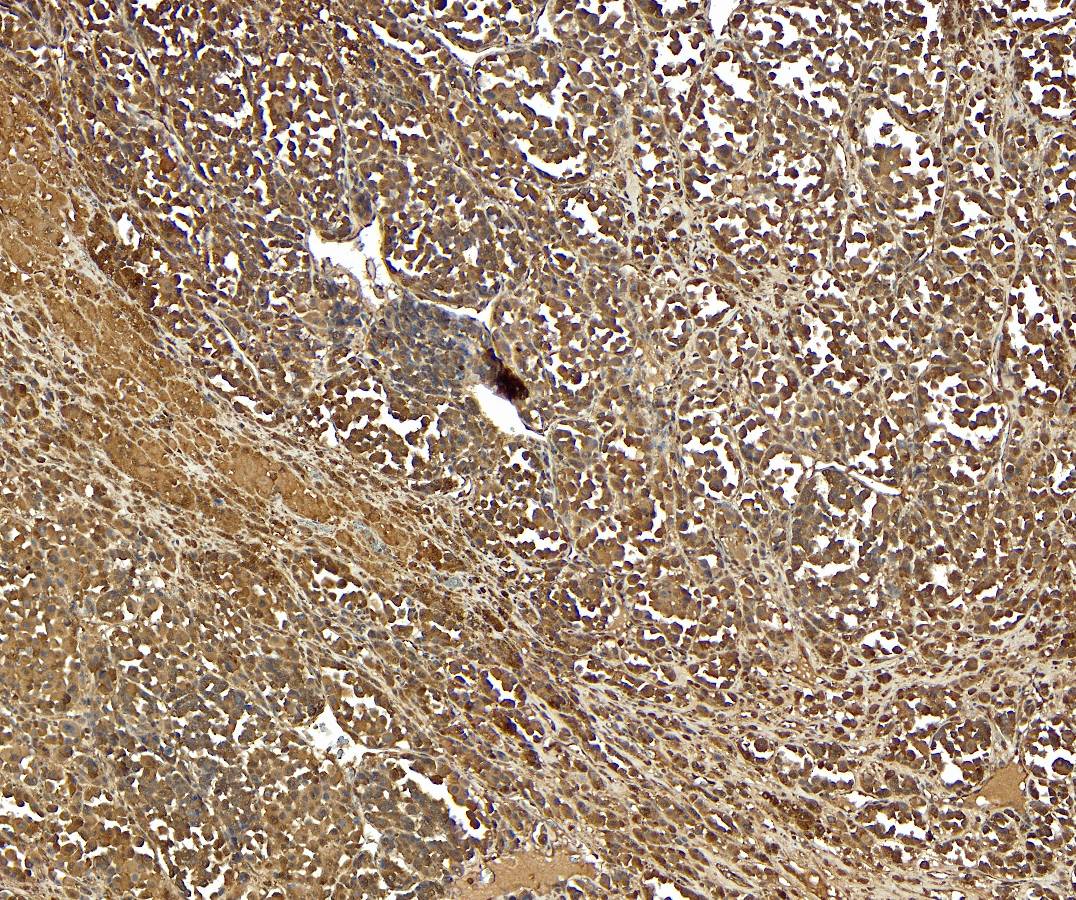

Formulation Supplied at 0.5 mg/ml in Tris saline, 0.02% sodium azide, pH7.3 with 0.5% bovine serum albumin.
| |
Unit Size 100 µg | |
Storage Instructions Aliquot and store at -20°C. Minimize freezing and thawing. | |
Synonym / Alias Names silver homolog|silver (mouse homolog)-like|silver (mouse homolog) like|Silver, mouse, homolog of|Pmel 17|Melanocyte protein mel 17|gp100|SIL|SI|ME20|D12S53E|SILV|PMEL17|silver homolog (mouse) | |
Accession ID NP_008859.1 | |
Blocking Peptide EBP07296 | |
Immunogen Peptide with sequence CPIGENSPLLSGQQ, from the C Terminus of the protein sequence according to NP_008859.1. | |
Peptide Sequence CPIGENSPLLSGQQ | |
Purification Method Purified from goat serum by ammonium sulphate precipitation followed by antigen affinity chromatography using the immunizing peptide. | |
Shipping Instructions Refrigerated | |
Predicted Species Human, Mouse | |
Reactive Species Human | |
Human Gene ID 6490 | |
Mouse Gene ID 20431 | |
Rat Gene ID 362818 | |
Product Grade  | |
IHC Results Paraffin embedded Human Melanoma. Recommended concentration: 6-7µg/ml. | |
ELISA Detection Limit Antibody detection limit dilution 1:32000. | |
Application Type Pep-ELISA, IHC |
Goat Anti-Silver homologue / Pmel 17 (C-terminus) Antibody
$431.00
| SKU | Unit Size | Price |
|---|---|---|
Select a unit size:
Selected References [{"pmid": 22542736, "intro": "This antibody (previous batch) has been successfully used in Western blot on Zebrafish:", "title": "Characterization of a bystander effect induced by the endocrine-disrupting chemical 6-propyl-2-thiouracil in zebrafish embryos.", "author": "Liu C, Yan W, Zhou B, Guo Y, Liu H, Yu H, Giesy JP, Wang J, Li G, Zhang X.", "journal": "Aquat Toxicol. 2012 Aug 15;118-119:108-15. "}] |
Documents |